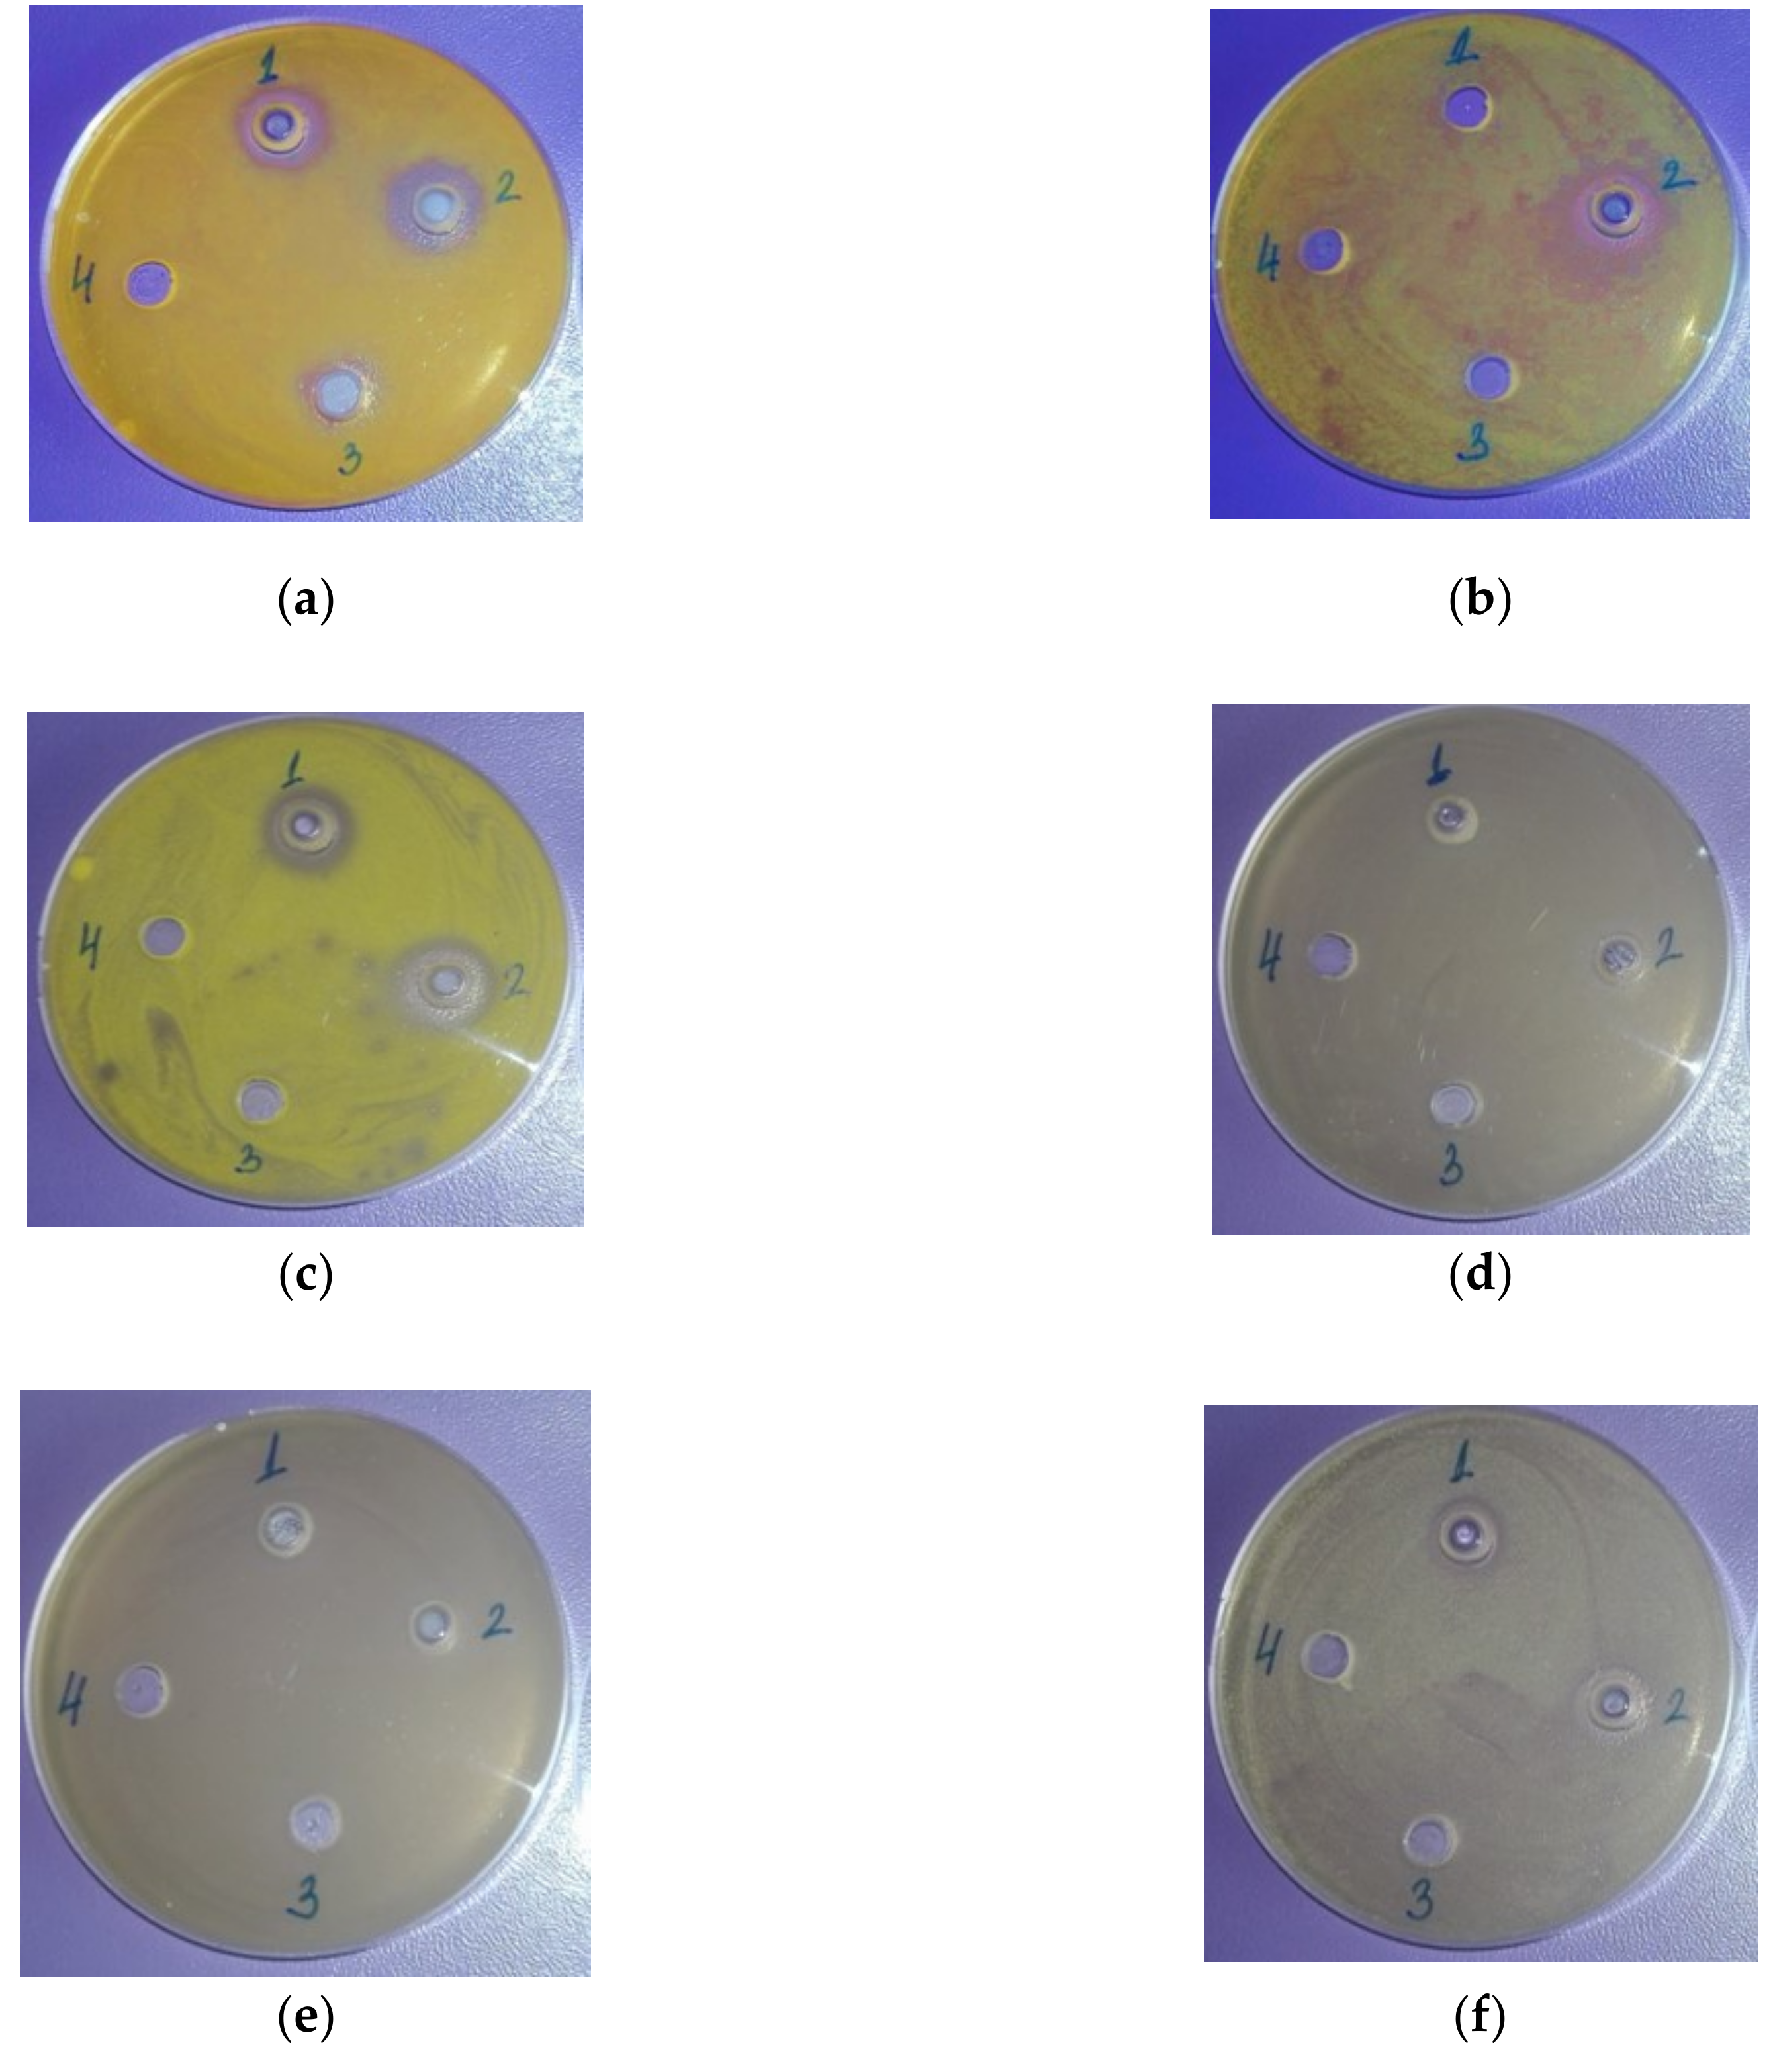

Chemical Composition and Antimicrobial Activity of Laurus nobilis L. Essential Oils from Bulgaria
Abstract
:1. Introduction
2. Results
2.1. Chemical Composition
2.2. Antimicrobial Activity
3. Discussion
4. Materials and Methods
4.1. Plant Material
4.2. Isolation of the Essential Oil
4.3. Gas Chromatographic (GC) Mass Spectroscopy (MS) Analyses of the Essential Oil
4.4. Antimicrobial Activity of the Essential Oil
4.5. Statistics
5. Conclusions
Author Contributions
Funding
Conflicts of Interest
References
- Georgiev, E.; Stoyanova, A. A Guide for the Specialist in the Aromatic Industry; UFT Academic Publishing House: Plovdiv, Bulgaria, 2006. [Google Scholar]
- Kilic, A.; Hafizoglu, H.; Kollmannsberger, H.; Nitz, S. Volatile constituents and key odorants in leaves, buds, flowers, and fruit of Laurus nobilis L. J. Agric. Food Chem. 2004, 52, 1601–1606. [Google Scholar] [CrossRef] [PubMed]
- Abu-Dahab, R.; Kasabri, V.; Afifi, F. Evaluation of the volatile oil composition and antiproliferative activity of Laurus nobilis L. (Lauraceae) on breast cancer cell line models. Rec. Nat. Prod. 2014, 8, 136–147. [Google Scholar]
- Loizzo, M.; Tundis, R.; Menichini, F.; Saab, A.; Satti, G.; Menichini, F. Cytotoxic activity of essential oils from Labiatae and Lauraceae families against in vitro human tumor models. Anticancer Res. 2007, 27, 3293–3300. [Google Scholar] [PubMed]
- Said, C.; Hűssein, K. Determination of the chemical and genetic differences of Laurus collected from three different geographic and climatic areas in Lebanon. Eur. Sci. J. 2014, 2, 412–419. [Google Scholar]
- Verdian-rizi, M.; Hadjiakhoondi, A. Essential oil composition of Laurus nobilis L. of different growth stages growing in Iran. Z. Naturforsch. C. 2008, 63, 785–788. [Google Scholar] [PubMed]
- Zekovic, Z.; Lepojevic, Z.; Mujic, I. Laurel extracts obtained by steam distillation, supercritical fluid and solvent extraction. J. Nat. Prod. 2009, 2, 104–109. [Google Scholar]
- Zolfaghari, B.; Samsam-Shariat, S.; Ghannadi, A. Chemical composition of volatile oils from the endocarp and hulls of Persian bay laurel fruit: A fragrant herb used in traditional Iranian medicine. JRPS 2013, 2, 1–4. [Google Scholar]
- Sangun, M.; Aydin, E.; Timur, M.; Karadeniz, H.; Caliskan, M.; Ozkan, A. Composition of chemical composition of the essential oil of Laurus nobilis L. leaves and fruit from different regions of Hatay. Turk. J Environ. Biol. 2007, 28, 731–733. [Google Scholar]
- Marzouki, H.; Piras, A.; Marongiu, B.; Rosa, A.; Assunta, M. Extraction and separation of volatile and fixed oils from berries of Laurus nobilis L. by supercritical CO2. Molecules 2008, 13, 1702–1711. [Google Scholar] [CrossRef] [PubMed]
- Amin, G.; Sourmaghi, M.; Jaafari, S.; Hadjagaee, R.; Yazdinezhad, A. Influence of phenological stages and method of distillation on Iranian cultivated bay leaves volatile oil. PJBS 2007, 10, 2895–2899. [Google Scholar] [PubMed]
- Bahmanzadegan, A.; Rowshan, V.; Zareian, F.; Alizaden, R.; Bahmanzadegan, M. Seasonal variation in volatile oil, polyphenol content and antioxidant activity in extract of Laurus nobilis grown in Iran. J. Pharm. Pharmacol. 2015, 3, 223–231. [Google Scholar] [CrossRef]
- Caputo, L.; Nazzaro, F.; Souza, L.F.; Aliberti, L.; De Martino, L.; Fratianni, F.; Coppola, R.; De Feo, V. Laurus nobilis: Composition of essential oil and its biological activities. Molecules 2017, 22, 930. [Google Scholar] [CrossRef] [PubMed]
- Derwich, E.; Benziane, Z.; Boukir, A. Chemical composition and antibacterial activity of leaves essential oil of Laurus nobilis from Marocco. AJBAS 2009, 3, 3818–3824. [Google Scholar]
- El, S.; Karagozlu, N.; Karakaya, S.; Sahin, S. Antioxidant and antimicrobial activities of essential oils extracted from Laurus nobilis L. leaves by using solvent-free microwave and hydrodistillation. FNS 2014, 5, 97–106. [Google Scholar] [CrossRef]
- El-Sawi, S.; Ibrahim, M.; Ali, A. In vitro cytotoxic, antioxidant and antimicrobial activities of essential oil of leaves of Laurus nobilis L. grown in Egypt and its chemical composition. Med. Aromat. Plant Sci. Biotechnol. 2009, 3, 16–23. [Google Scholar]
- Fernandez-Andrade, C.; da Rosa, M.; Boufleuer, E.; Ferreira, F.; Iwanaga, C.; Gonçalves, J.; Cortez, D.; Martins, C.; Linde, G.; Simões, M.; et al. Chemical composition and antifungal activity of essential oil and fractions extracted from the leaves of Laurus nobilis L. cultivated in southern Brazil. J. Med. Plants Res. 2016, 48, 865–871. [Google Scholar]
- Ivanovich, J.; Misic, D.; Ristic, M.; Pesic, O.; Zizovic, I. Supercritical CO2 extract and essential oil of bay (Laurus nobilis L.)—Chemical composition and antimicrobial activity. J. Serb. Chem. Soc. 2010, 75, 395–404. [Google Scholar] [CrossRef]
- Moghtader, M.; Salari, H. Comparative survey on the essential oil composition from the leaves and flowers of Laurus nobilis L. from Kerman province. J. Ecol. Nat. Environ. 2012, 4, 150–153. [Google Scholar] [CrossRef]
- Ozek, T. Distillation parameters for pilot plant production of Laurus nobilis essential oil. Rec. Nat. Prod. 2012, 6, 135–143. [Google Scholar]
- Politeo, O.; Jukic, M.; Milos, M. Chemical composition and antioxidant activity of free volatile aglycones from laurel (Laurus nobilis L.) compared to its essential oil. Croat. Chem. Acta 2007, 80, 121–126. [Google Scholar]
- Shokoohinna, Y.; Yegdaneh, A.; Аmin, G.; Ghannadi, A. Seasonal variations of Laurus nobilis L. leaves volatile oil constituent in Isfahan. RJP 2014, 1, 1–6. [Google Scholar]
- Tanab, A.; Saharkhiz, M.; Niakousari, M. Sweet bay (Laurus nobilis L.) essential oil and its chemical composition, antioxidant activity and leaf micromorphology under different extraction methods. Sustain. Chem. Pharm. 2018, 9, 12–18. [Google Scholar]
- Tayoub, G.; Oden, A.; Ghanem, I. Chemical composition and fumigation toxicity of Laurus nobilis L. and Salvia officinalis L. essential oils on larvae of khapra beetle (Trogoderma granarium Everts). Herba Pol. 2012, 58, 26–37. [Google Scholar]
- Naderi-Hajibaghercandi, M.; Sefidkon, P.; Poorherave, M.; Mirza, M. Extraction, identification and comparison of chemical composition of the stem, leaf and flower essential oil from Laurus nobilis L. Iranian J. Med. Aromat. Plants 2009, 25, 216–227. [Google Scholar]
- Goudjil, M.; Ladjel, S.; Bencheikh, S.; Zighmi, S.; Hamada, D. Study of the chemical composition, antibacrterial and antioxidant activities of the essential oil extracted from the leaves of Algerian Laurus nobilis Lauraceae. J. Chem. Pharm. Res. 2015, 7, 379–385. [Google Scholar]
- Sarkic, A.; Stappen, I. Essential Oils and Their Single Compounds in Cosmetics—A Critical Review. Cosmetics 2018, 5, 11. [Google Scholar] [CrossRef]
- Bras, S.; Mendes-Bastos, P.; Amaro, C.; Cardoso, J. Allergic contact dermatitis caused by laurel leaf oil. Contact Dermat. 2015, 72, 398–421. [Google Scholar] [CrossRef] [PubMed]
- Baser, K.H.C.; Buchbauer, G. Handbook of Essential Oils: Science, Technology, and Applications, 2nd ed.; CRC Press: Abingdon, UK, 2015. [Google Scholar]
- Kaurinovic, B.; Popovic, M.; Vlaisavljevic, S. In vitro and in vivo effects of Laurus nobilis L. leaf extracts. Molecules 2010, 15, 3378–3390. [Google Scholar] [CrossRef] [PubMed]
- Jemâa, J.M.B.; Tersim, N.; Toudert, K.T.; Khouja, M.L. Insecticidal activities of essential oils from leaves of Laurus nobilis L. from Tunisia, Algeria and Morocco, and comparative chemical composition. J. Stored Prod. Res. 2012, 48, 97–104. [Google Scholar]
- Ekren, S.; Yerlikaya, O.; Tokul, H.E.; Akpınar, A.; Acu, M. Chemical composition, antimicrobial activity and antioxidant capacity of some medicinal and aromatic plant extracts. Afr. J. Microbiol. Res. 2013, 7, 383–388. [Google Scholar]
- Snuossi, M.; Trabelsi, N.; Ben Taleb, S.; Dehmeni, A.; Flamini, G.; de Feo, V. Laurus nobilis, Zingiber officinale and Anethum graveolens essential oils: Composition, antioxidant and antibacterial activities against bacteria isolated from fish and shellfish. Molecules 2016, 21, 1414. [Google Scholar] [CrossRef] [PubMed]
- Vasundhara, M.; Gujaran, S.; Jayaram, A.; Priyanka, R. Sweet bay (Laurus nobilis L.) essential oil: A study on its application in dentistry. WJPR 2016, 5, 2049–2057. [Google Scholar]
- Topalov, P. Raw Material Science for Essential Oils and Vegetable Fats; Hr. Danov Press: Plovdiv, Bulgaria, 1962; pp. 187–190. [Google Scholar]
- Georgiev, E.; Lazarov, K. Essential oil of Bulgarian laurel. Food Ind. 1992, 1, 31–33. [Google Scholar]
- Products—Ingredient Labelling. Help Note for Dermatologists. Available online: http: //ec.europa.eu/consumers/sectors/cosmetics/files/doc/guide_labelling200802_en.pf (accessed on 20 February 2019).
- Bauer, K.; Garbe, D.; Surburg, H. Common Fragrance and Flavor Materials; Preparation, Properties and Uses, Fourth Completely Revised Edition; Wiley-VCH: Weinheim, Germany, 2016. [Google Scholar]
- Moghtader, M.; Farahmand, A. Evaluation of the antibacterial effects of essential oil from the leaves of Laurus nobilis L. in Kerman Province. J. Microbiol. Antimicrob. 2013, 5, 13–17. [Google Scholar] [CrossRef]
- Siriken, B.; Yavuz, C.; Güler, A. Antibacterial Activity of Laurus nobilis: A review of literature. Med. Sci. Discov. 2018, 5, 374–379. [Google Scholar] [CrossRef]
- Ramos, C.; Teixeira, B.; Batista, I.; Matos, O.; Serrano, C.; Neng, N.R.; Nogueira, J.M.F.; Nunes, M.L.; Marques, A. Antioxidant and antibacterial activity of essential oil and extracts of bay laurel Laurus nobilis Linnaeus (Lauraceae) from Portugal. Nat. Prod. Res. 2012, 26, 518–529. [Google Scholar] [CrossRef] [PubMed]
- Tajkarimi, M.M.; Ibrahim, S.A.; Cliver, D.O. Antimicrobial herb and spice compounds in food. Food Control 2010, 21, 1199–1218. [Google Scholar] [CrossRef]
- Pejin, B.; Savic, A.; Sokovic, M.; Glamoclija, J.; Ciric, A.; Nikolovic, M. Further in vitro evaluation of antiradical and antimicrobial activities of phytol. Nat. Prod. Res. 2014, 28, 372–376. [Google Scholar] [CrossRef] [PubMed]
- Pejin, B.; Kojic, V.; Bogdanovic, G. An insight into the cytotoxic activity of phytol at in vitro conditions. Nat. Prod. Res. 2014, 28, 2053–2056. [Google Scholar] [CrossRef] [PubMed]
- Pejin, B.; Ciric, A.; Glamoclija, J.; Nikolic, M.; Sokovic, M. In vitro anti-quorum sensing activity of phytol. Nat. Prod. Res. 2015, 29, 374–377. [Google Scholar] [CrossRef] [PubMed]
- The State Pharmacopoeia of the USSR, 11th ed.; Medizina: Moscow, Russia, 1990.
- Balinova, A.; Diakov, G. On improved apparatus for microdistillation of rose flowers. Plant Sci. 1974, 11, 79–85. [Google Scholar]
- Balouiri, M.; Sadiki, M.; Koraichi Ibnsouda, S. Methods for in vitro evaluating antimicrobial activity: A review. J. Pharm. Anal. 2016, 6, 71–79. [Google Scholar] [CrossRef] [PubMed]
Sample Availability: No samples of the compounds are available from the authors. |

| № | Compounds | RI | Content, % | ||
|---|---|---|---|---|---|
| Fruits | Twigs | Leaves | |||
| 1 | α-Thujene | 931 | nd * | 0.29 ± 0.00 | 0.32 ± 0.00 |
| 2 | α-Pinene | 939 | 11.01 ± 0.15 | 2.94 ± 0.03 | 2.56 ± 0.03 |
| 3 | Camphene | 954 | 4.33 ± 0.05 | 0.30 ± 0.00 | 0.18 ± 0.00 |
| 4 | Sabinene | 971 | 6.30 ± 0.07 | 3.33 ± 0.07 | 8.82 ± 0.13 |
| 5 | β-Pinene | 979 | 0.28 ± 0.00 | 3.44 ± 0.07 | 2.45 ± 0.06 |
| 6 | β-Myrcene | 991 | 0.34 ± 0.00 | 0.19 ± 0.00 | 0.31 ± 0.00 |
| 7 | α-Phellandrene | 1003 | 5.18 ± 0.06 | 0.38 ± 0.00 | 1.01 ± 0.02 |
| 8 | α-Terpinene | 1014 | 0.22 ± 0.00 | 0.89 ± 0.00 | 0.52 ± 0.00 |
| 9 | p-Cymene | 1020 | nd | 1.00 ± 0.02 | 0.18 ± 0.00 |
| 10 | Limonene | 1029 | 2.25 ± 0.04 | 1.68 ± 0.03 | 0.04 ± 0.00 |
| 11 | 1,8-cineole | 1032 | 33.33 ± 0.70 | 48.53 ± 0.75 | 41.02 ± 0.71 |
| 12 | cis-β-ocimene | 1046 | 0.16 ± 0.00 | nd | nd |
| 13 | trans-β-ocimene | 1050 | 0.72 ± 0.00 | nd | nd |
| 14 | γ-Terpinene | 1055 | 0.44 ± 0.00 | 1.35 ± 0.03 | 0.99 ± 0.02 |
| 15 | cis-Sabinene hydrate | 1065 | nd | nd | 0.62 ± 0.00 |
| 16 | β-Linalool | 1096 | 2.16 ± 0.06 | 3.80 ± 0.07 | 4.92 ± 0.08 |
| 17 | Terpinene-4-ol | 1179 | 0.85 ± 0.00 | 3.25 ± 0.07 | 2.35 ± 0.04 |
| 18 | α-Terpineol | 1189 | 1.55 ± 0.04 | 1.73 ± 0.05 | 3.11 ± 0.06 |
| 19 | Bornyl acetate | 1286 | 4.38 ± 0.08 | 0.52 ± 0.00 | 0.65 ± 0.00 |
| 20 | α-Terpinyl acetate | 1333 | 10.30 ± 0.30 | 13.09 ± 0.33 | 14.44 ± 0.35 |
| 21 | Thymol | 1336 | 0.20 ± 0.00 | 0.70 ± 0.00 | 0.15 ± 0.00 |
| 22 | Eugenol | 1363 | 0.21 ± 0.00 | 0.33 ± 0.00 | 1.47 ± 0.02 |
| 23 | β-Elemene | 1390 | 7.45 ± 0.07 | 0.25 ± 0.00 | 0.78 ± 0.00 |
| 24 | Methyleugenol | 1402 | 1.58 ± 0.04 | 6.62 ± 0.06 | 6.03 ± 0.06 |
| 25 | β-Caryophyllene | 1429 | 0.51 ± 0.00 | 0.35 ± 0.00 | 0.32 ± 0.00 |
| 26 | Germacrene D | 1484 | nd | nd | 0.25 ± 0.00 |
| 27 | Bicyclogermacrene | 1501 | nd | nd | 0.16 ± 0.00 |
| 28 | Caryophyllene oxide | 1574 | 0.61 ± 0.00 | 0.41 ± 0.00 | 0.34 ± 0.00 |
| 29 | Ledol | 1602 | 0.31 ± 0.00 | 0.27 ± 0.00 | 0.39 ± 0.00 |
| 30 | (−)-Spathulenol | 1619 | 0.25 ± 0.00 | 0.21 ± 0.00 | 0.31 ± 0.00 |
| 31 | τ-Cadinol | 1628 | 0.44 ± 0.00 | 0.38 ± 0.00 | 0.55 ± 0.00 |
| 32 | β-Eudesmol | 1642 | 0.37 ± 0.00 | 0.32 ± 0.00 | 0.47 ± 0.00 |
| 34 | Cedren-13-ol acetate<8-> | 1788 | 0.97 ± 0.00 | nd | nd |
| 34 | n-Heneicosane | 2100 | 0.19 ± 0.00 | 0.16 ± 0.00 | 0.24 ± 0.00 |
| 35 | Phytol | 2105 | 0.21 ± 0.00 | 0.18 ± 0.00 | 0.26 ± 0.00 |
| 36 | n-Docosane | 2200 | 0.21 ± 0.00 | 0.18 ± 0.00 | 0.26 ± 0.00 |
| 37 | n-Tricosane | 2300 | 0.19 ± 0.00 | 0.17 ± 0.00 | 0.23 ± 0.00 |
| 38 | n-Tetracosane | 2400 | 0.16 ± 0.00 | 0.15 ± 0.00 | 0.20 ± 0.00 |
| 39 | n-Pentacosane | 2500 | 0.24 ± 0.00 | 0.21 ± 0.00 | 0.30 ± 0.00 |
| 40 | n-Hexacosane | 2600 | 0.39 ± 0.00 | 0.34 ± 0.00 | 0.49 ± 0.00 |
| 41 | n-Heptacosane | 2700 | 0.33 ± 0.00 | 0.28 ± 0.00 | 0.40 ± 0.00 |
| 42 | n-Octacosane | 2800 | 0.26 ± 0.00 | 0.23 ± 0.00 | 0.33 ± 0.00 |
| 43 | Squalene | 2817 | 0.41 ± 0.00 | 0.35 ± 0.00 | 0.51 ± 0.00 |
| Total identified compounds, % | 99.29 | 98.80 | 98.93 | ||
| Hydrocarbons, % | 1.98 | 1.74 | 2.48 | ||
| Monoterpene hydrocarbons, % | 31.45 | 14.97 | 17.38 | ||
| Oxygen monoterpenes, % | 52.95 | 71.78 | 67.84 | ||
| Sesquiterpene hydrocarbons, % | 8.02 | 0.61 | 1.53 | ||
| Oxygen sesquiterpenes, % | 2.97 | 1.61 | 2.08 | ||
| Phenyl propanoids, % | 2.00 | 8.76 | 7.91 | ||
| Diterpenes, % | 0.21 | 0.18 | 0.26 | ||
| Triterpenes, % | 0.41 | 0.35 | 0.52 | ||
| Test Microorganisms | Inhibition Zone, mm | ||
|---|---|---|---|
| Fruit EO | Twigs EO | Leaves EO | |
| Staphylococcus aureus ATCC 6538 | 12.9 ± 0.02 | 11.4 ± 0.05 | 15.1 ± 0.02 |
| Bacillus subtilis ATCC 6633 | 8.0 ± 0.00 | 8.0 ± 0.00 | 13.6 ± 0.05 |
| Kocuria rhizophila ATCC 9341 | 11.6 ± 0.05 | 8.0 ± 0.00 | 13.0 ± 0.00 |
| Escherichia coli ATCC 8739 | 8.0 ± 0.00 | 8.0 ± 0.00 | 8.0 ± 0.00 |
| Pseudomonas aeruginosa ATCC 9027 | 8.0 ± 0.00 | 8.0 ± 0.00 | 8.0 ± 0.00 |
| Salmonela abony NCTC 6017 | 11.3 ± 0.02 | 8.0 ± 0.00 | 12.2 ± 0.04 |
| Candida albicans ATCC 10231 | 8.0 ± 0.00 | 8.0 ± 0.00 | 16.4 ± 0.02 |
| Saccharomyces cerevisiae ATCC 2601 | 15.7 ± 0.04 | 8.0 ± 0.00 | 33.3 ± 0.00 |
| Aspergillus brasiliensis ATCC 16404 | 10.8 ± 0.02 | 8.0 ± 0.00 | 14.8 ± 0.05 |
© 2019 by the authors. Licensee MDPI, Basel, Switzerland. This article is an open access article distributed under the terms and conditions of the Creative Commons Attribution (CC BY) license (http://creativecommons.org/licenses/by/4.0/).
Share and Cite
Fidan, H.; Stefanova, G.; Kostova, I.; Stankov, S.; Damyanova, S.; Stoyanova, A.; Zheljazkov, V.D. Chemical Composition and Antimicrobial Activity of Laurus nobilis L. Essential Oils from Bulgaria. Molecules 2019, 24, 804. https://doi.org/10.3390/molecules24040804
Fidan H, Stefanova G, Kostova I, Stankov S, Damyanova S, Stoyanova A, Zheljazkov VD. Chemical Composition and Antimicrobial Activity of Laurus nobilis L. Essential Oils from Bulgaria. Molecules. 2019; 24(4):804. https://doi.org/10.3390/molecules24040804
Chicago/Turabian StyleFidan, Hafize, Galina Stefanova, Iliana Kostova, Stanko Stankov, Stanka Damyanova, Albena Stoyanova, and Valtcho D. Zheljazkov. 2019. "Chemical Composition and Antimicrobial Activity of Laurus nobilis L. Essential Oils from Bulgaria" Molecules 24, no. 4: 804. https://doi.org/10.3390/molecules24040804
APA StyleFidan, H., Stefanova, G., Kostova, I., Stankov, S., Damyanova, S., Stoyanova, A., & Zheljazkov, V. D. (2019). Chemical Composition and Antimicrobial Activity of Laurus nobilis L. Essential Oils from Bulgaria. Molecules, 24(4), 804. https://doi.org/10.3390/molecules24040804

